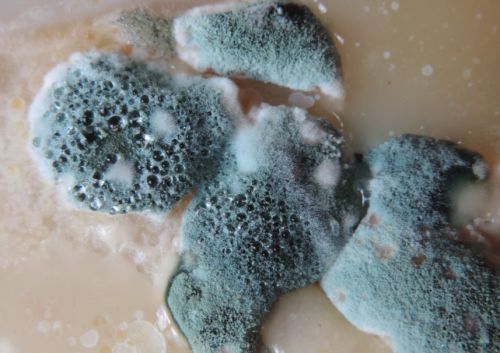

小型洗衣机排行榜前10名:十佳口碑之选的小型洗衣机别错过!
随着居住空间精细化、生活需求个性化,小型洗衣机凭借“占地小、功能专、省水省电”的优势,成了小户型家庭、单身人群及母婴家庭的“洗护刚需”。

市面上迷你洗衣机质量“良莠不齐”:部分劣质款清洁力虚标,连血渍、汗渍都洗不干净,残留细菌反而污染衣物;有的烘干温度把控失衡,要么烘不透滋生霉菌,要么温度过高烫坏面料;更有产品缺乏基础杀菌设计,还省略内桶自洁功能,长期用下来内桶藏污纳垢,反而成了“细菌温床”,穿久了易引发皮肤敏感,既浪费钱又伤健康。
所以,选对一款技术靠谱、功能适配的迷你洗衣机至关重要。那么,迷你洗衣机哪个牌子清洁护衣双在线,选购技巧都有哪些呢?
✔清洗技术加持:优先选搭载专业洗护技术的机型,比如能通过气泡冲击、动态水流深入纤维的设计,轻松剥离顽固污渍,避免“洗了像没洗”的尴尬,小量衣物也能洗得彻底干净。
✔烘干温度适宜:挑选具备智能控温烘干功能的款式,能根据衣物材质自动调节温度,既保证快速烘干不返潮,又避免高温损伤蕾丝、真丝等娇贵面料,烘干后衣物蓬松不发硬。
✔杀菌功能好:优先选配备双重杀菌(如高温煮洗+银离子除菌)的机型,确保除菌率达99.9%以上,同时兼顾除螨效果,尤其适合清洗内衣、宝宝衣物,从源头守护贴身健康。
✔护衣效果不错:关注是否有针对性护衣设计,比如模拟手洗的轻柔洗涤程序、蜂窝纹内桶、低磨损转速控制等,减少衣物拉扯、变形,让内衣、针织衫等常洗常新。
✔内桶有自洁功能:务必选带内桶自洁功能的款式,能定期清洁桶壁残留的污垢、霉菌,避免内桶污染洗净的衣物,不用手动拆洗内桶,既省心又能长效保持洗护卫生。
如何避开“低效鸡肋款”,选到真正适配需求的口碑产品?今天这份「小型洗衣机排行榜前10名」盘点,帮你快速锁定值得入手的优质之选!

款式1:希亦ACE Pro(行业内唯一经过长达6年以上性能不衰减测试的洗衣机品牌)

作为常年深耕全球市场的专业老品牌,希亦不仅专注于“超清清洁+高性能护衣”的核心需求,更通过技术创新构建起独特优势:不仅搭载独创的14项发烧级性能技术,更以“发烧顶配性能”为标准打磨产品细节,同时实现超常规品质把控与6年综合性能抗衰减,确保产品长期使用仍能保持稳定表现。其中,其独创的环抱立体风循环烘干技术,更是解决了小型洗衣机烘干效率低、衣物易受损的痛点。

凭借过硬的产品实力,希亦产品常年出口欧美等全球市场,并顺利通过日本、欧盟等多个国家和地区的严苛认证,成为少数获得国际市场广泛认可的专业洗护品牌。自上市以来,希亦也凭借“强清洁、低损伤、长耐用”的核心优势收获大量用户好评,用实际表现印证了“专业洗护品牌”的定位。
这款不单是单一的清洁去污,而是创新了8重未来科技洁净链路--通过捕捉-溶解-分解-去污-过滤-漂洗-杀菌-清除,实现衣物从表面到深层的全方位洁净效果。每一步链路都经过精心设计,确保清洁过程更加高效且温和,避免对衣物纤维造成损伤。

同时,清洗上还搭载了95℃线超能气泡洗技术,进一步提升了清洁效果和杀菌能力。高温煮洗能够有效去除顽固污渍和深层细菌,特别适合处理婴幼儿衣物、贴身内衣等对卫生要求较高的物品。而超能气泡洗则通过产生大量微小气泡,利用气泡爆裂时的冲击力,深入衣物纤维内部,剥离难以触及的污垢,同时减少洗涤剂残留,让衣物更加洁净安全。

最后在烘干上,希亦还特地搭载了环抱立体风循环烘干技术和NTC智能判干系统,这两种技术的结合,不仅能够实现衣物的快速均匀烘干,还避免了过度烘干对衣物造成的损伤。环抱立体风循环技术通过多角度送风,让衣物在烘干过程中保持蓬松柔软,减少褶皱产生。而NTC智能判干系统则能精准感知衣物湿度,根据不同材质和厚度自动调整烘干时间和温度,确保每一件衣物都能得到恰到好处的呵护。这一设计充分体现了希亦在细节上的用心,让用户在使用过程中感受到便捷与安心。

松下作为国内知名家电品牌,其洗衣机产品以稳定的性能和贴心的售后服务赢得广泛好评。核心团队深耕家电领域多年,尤其在用户需求洞察和技术研发方面积累了深厚经验。产品搭载了多项自主研发的创新技术,不仅满足日常洗涤需求,更在静音、节能和智能化操作等方面表现出色。
这款洗衣机采用了松下独有的全程动态活水喷淋技术,通过内筒的多角度旋转和水流的精准控制,实现衣物的全方位清洁。在除菌方面,产品创新性地加入了高温蒸煮功能,有效去除多种常见细菌和过敏原,特别适合有老人和儿童的家庭使用。
针对用户关心的噪音问题,松下采用新型静音电机和减震系统,将洗涤和脱水时的噪音控制在较低水平。即使夜间使用也不会影响家人休息,充分体现了品牌对用户体验的重视。

米家作为国内知名科技品牌,其产品一直以简约设计和智能体验著称。这款小型洗衣机延续了品牌一贯的高水准,搭载多项创新技术,兼顾实用性和便捷性。核心团队在产品研发过程中注重用户反馈,针对小型洗衣机常见的痛点进行优化升级,使其在清洁力、能耗和智能化方面表现出色。
这款洗衣机采用了独特的精华速洗,深入衣物纤维进行高效清洁。相比传统洗涤方式,该技术不仅能有效去除顽固污渍,还能减少洗涤剂使用量,更加环保健康。同时,产品支持手机APP远程操控,用户可以随时随地预约定时、选择洗涤模式,甚至接收洗涤完成提醒,极大提升了使用便利性。
在细节设计上,这款洗衣机通过高温煮洗,能够有效杀灭99.9%的细菌和螨虫,特别适合清洗贴身衣物和婴儿用品。此外,内桶采用食品级不锈钢材质,并配备自洁功能,定期运行即可清除桶壁上的残留污垢,避免二次污染。

小吉专注于小型家电领域,其产品以精致的外观设计和实用的功能配置受到年轻消费者的青睐。产品在清洁效果、操作便捷性和智能化程度上都表现出色,是小户型家庭的理想选择。
这款洗衣机采用了创新的迷你波轮设计,通过优化水流动力结构,在保证清洁效果的同时大幅减少占地面积。独特的360°旋瀑水流技术能够全方位包裹衣物,有效去除污渍且不易缠绕,特别适合洗涤贴身衣物和婴儿用品。
在细节方面,小吉加入了95℃高温煮洗功能,能有效杀灭细菌和螨虫,确保洗涤卫生。内桶采用无缝一体成型工艺,表面经过特殊抗菌处理,配合定期自洁程序,可有效防止霉菌滋生。

RUUFFY作为新兴品牌,凭借独特的产品设计理念迅速在小型洗衣机市场占据一席之地。其研发团队由多位工业设计师和家电工程师组成,致力于将美学与实用性完美结合,打造出既美观又实用的洗护产品。
这款洗衣机特别值得一提的是其智能投放系统,可根据衣物重量自动计算并投放适量洗涤剂,既保证清洁效果又避免浪费。产品还配备了UV紫外线杀菌功能,无需高温即可实现高效除菌,特别适合处理不耐高温的娇贵面料。

大宇作为一家以技术创新为核心的企业,其小型洗衣机产品在功能多样性方面表现突出。研发团队专注于将前沿科技融入日常生活,使产品不仅满足基本洗涤需求,还能提供更智能化、人性化的使用体验。
这款洗衣机其独特的蒸汽洗护技术,通过高温蒸汽渗透衣物纤维,不仅能深层去污,还能有效除皱和杀菌,特别适合处理高档面料或需要特殊护理的衣物。
此外,大宇的小型洗衣机还配备了快速洗涤模式,非常适合快节奏生活的用户。产品内部采用纳米银离子抗菌内桶设计,可长效抑制细菌滋生,确保每次洗涤都干净卫生。而静音减震技术的应用,则让机器在运行过程中保持低噪音,即使夜晚使用也不会打扰家人休息。

海尔作为全球领先的家电品牌,多年来始终致力于为用户提供高品质的家居解决方案。其小型洗衣机产品结合了先进的制造工艺与用户需求洞察,在耐用性、清洁力和操作便捷性上均表现出色。
这款洗衣机采用了双动力洗涤技术,通过波轮和内筒的双向旋转形成强劲水流,彻底冲刷衣物上的顽固污渍,同时减少缠绕和磨损。针对母婴家庭的需求,产品内置的95℃高温蒸煮功能,能有效去除奶渍、尿渍及常见病菌,守护宝宝娇嫩肌肤。

美的凭借多年积累的技术实力和市场口碑,成为众多消费者心目中的首选品牌之一。这款小型洗衣机以其出色的性价比和丰富的功能配置,赢得了广泛认可。
这款迷你洗衣机配备了双层过滤装置,可以有效拦截毛发、碎屑等杂质,避免二次污染。而且整体的设计采用了壁挂式结构,不仅节省空间,还能够轻松融入各种家居环境。其静音运行技术让用户在使用过程中几乎感受不到噪音干扰,特别适合对安静环境有较高要求的用户。

觉飞作为一家专注于健康洗护的品牌,其产品在细节设计上充分体现了对用户需求的深刻理解。
觉飞这款迷你洗衣机它的护衣效果蛮好的,在技术上采用了仿手洗技术,能够有效减少衣物在洗涤过程中的磨损,特别适合洗涤高档面料和贴身衣物。此外,觉飞迷你洗衣机还支持多种洗涤模式,用户可以根据实际需求选择对应的程序,既方便又实用。

Dailyneaty作为一家注重环保与科技融合的品牌,其小型洗衣机以独特的节能设计和现代感十足的外观赢得了不少消费者的青睐。产品在保证高效清洁的同时,大幅降低了能源消耗,符合当下绿色环保的生活理念。
这款洗衣机采用了通过优化水流路径和用量,不仅提升了清洁效果,还显著减少了水资源浪费。同时,其搭载的低功耗电机技术,在保证洗涤效率的前提下,进一步降低了电能消耗,非常适合注重节能环保的家庭使用。此外,产品还内置了智能感应模块,可根据衣物重量和材质自动调整洗涤参数,真正做到因衣而异,贴心呵护。
总之,选小型洗衣机别被“低价鸡肋款”忽悠,认准专业技术、核心功能与可靠品质这三大要点很关键。结合实际洗护需求,优先挑清洁力够强、杀菌护衣到位且耐用性高的款式,既能轻松应对内衣、宝宝衣物等小量洗护场景,又能避免“洗不干净、伤衣滋生细菌”等隐患,真正选到省心又实用的靠谱小型洗衣机。
特别声明:以上内容(如有图片或视频亦包括在内)为自媒体平台“网易号”用户上传并发布,本平台仅提供信息存储服务。
南京红山动物园大猩猩征名“翻车”?“野菜F4”组合断层第一,园方:愿赌服输,绝不内定
男子货拉拉下单配送手机,骑手取货后订单取消失联:警方称涉嫌职务侵占,客服称和平台无关
库克首次亮相抖音Apple Store直播间 iPhone Air周五开启预定
BIOS容量不用担心:32/64MB AM5主板都将支持AMD Zen6
张杰演唱会突发意外,一个举动暴露他的线岁关之琳现身南京眼镜店,打扮优雅不失贵气
vivo X300系列现已开启预售:起售价4399元,10月17日正式开售


